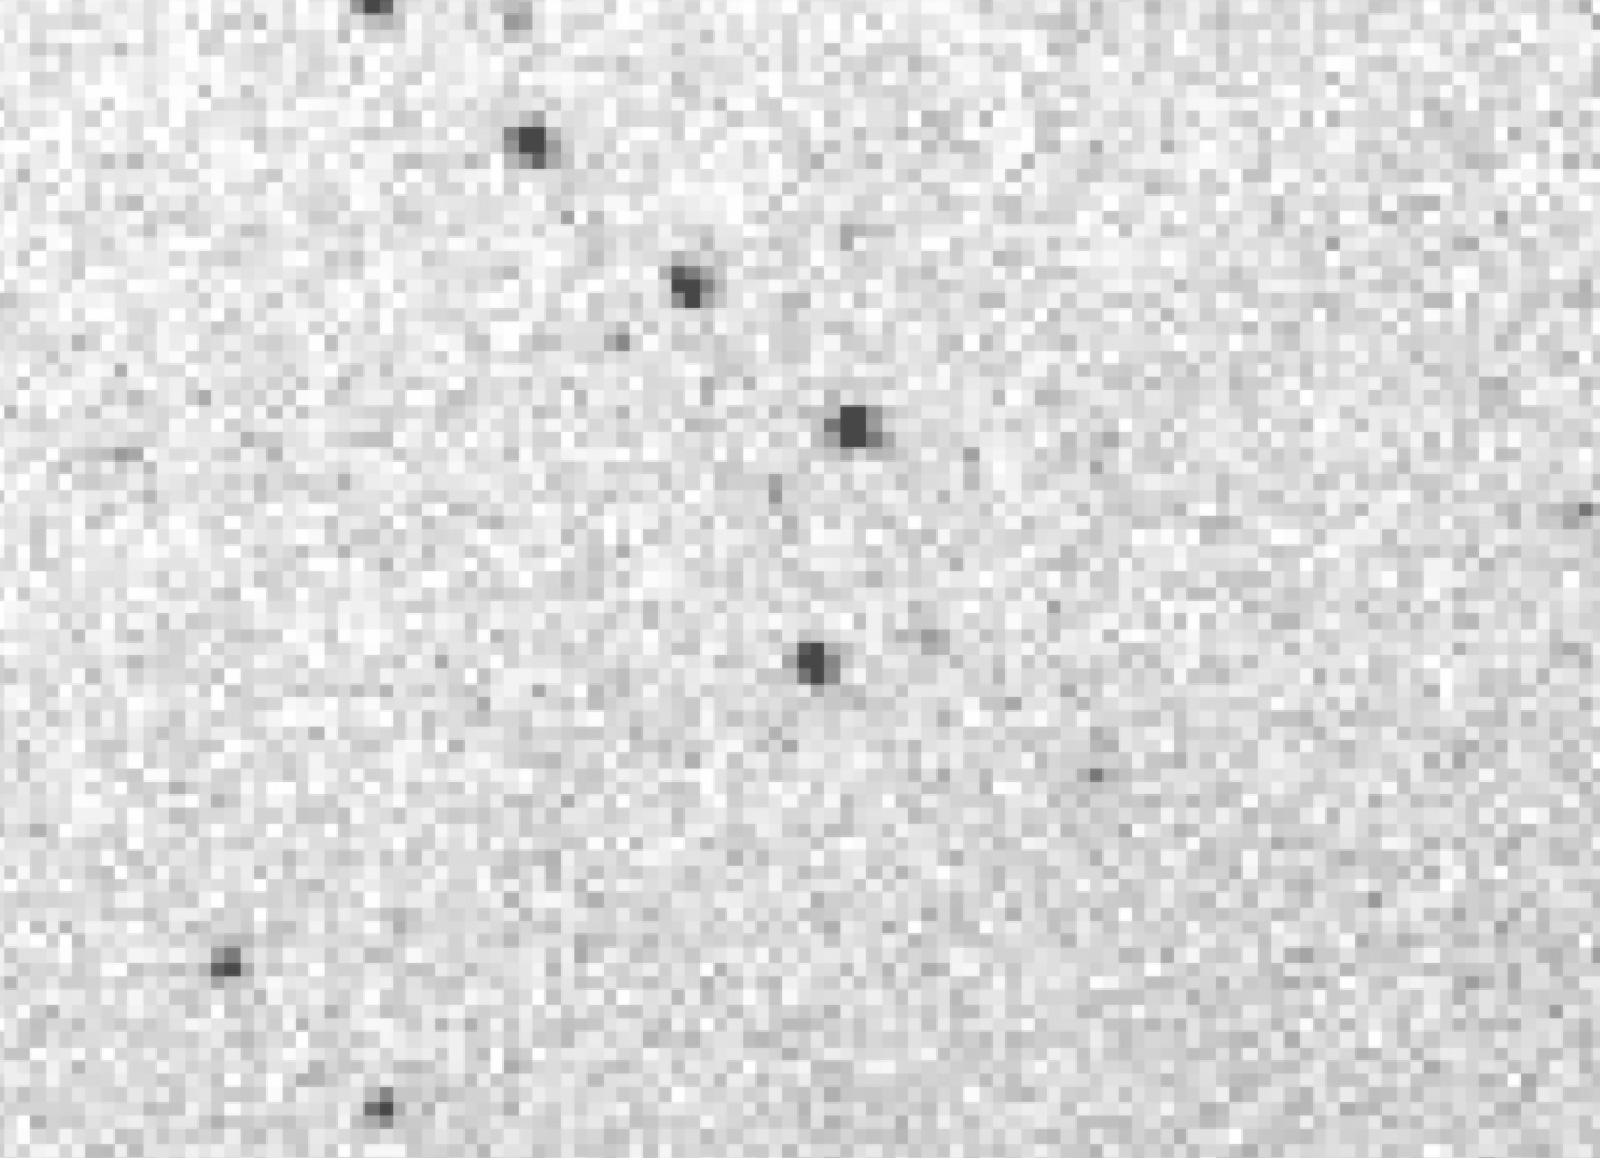

In this issue

No. 6
Spring 2020
Palomar Science Highlight: New Class of Interior to Venus Asteroid Newly Discovered at Palomar
By Bryce Bolin (Caltech/IPAC)
There is a tradition of naming new classes of asteroids after the first one of its type to be discovered, a tradition that has been followed in the past at Palomar Observatory. On January 7, 1976, Palomar astronomer Eleanor Helin using the then Palomar 18-inch Schmidt telescope discovered the first asteroid that crosses Earth’s orbit and has a mean orbital distance of less than 1 au, 2062 Aten which was the first of what later became the Aten class of asteroids. Almost exactly 44 years later after the discovery of the Aten asteroids, the first known asteroid to be located entirely within the orbit of Venus, 2020 AV2 was found by the Zwicky Transient Facility (ZTF) currently operating on the 48-inch Samuel Oschin Telescope during evening twilight on January 4, 2020. ZTF, an international collaboration of multiple institutions led by Caltech, has been searching for near-Sun objects during twilight. Several other ground-based surveys had searched for interior to Venus asteroids in the past, but no members of this new interior to Venus class of asteroids had been observed before.
Immediate follow-up observations were carried out with the help from Jennifer Milburn from Palomar Observatory using the optical and near infrared imaging cameras WaSP and WIRC on the 200-inch. The data revealed that 2020 AV2 has a stony-like composition typical for an asteroid located so close to the Sun. In addition, orbit-refining observations from the Palomar 60-inch telescope revealed the orbital evolutionary history, which suggests that the object had been in a stable location in the Solar System for tens of millions of years. The question is, are interior to Venus asteroids like 2020 AV2 a fluke oddity or are there more that remain to be found? The true test will require additional observations to search for more asteroids like 2020 AV2, but one implication of its discovery is that there may be more to be found. If their discovery is confirmed, the presence of additional 2020 AV2-like asteroids may imply that the Solar System inside the orbits of the terrestrial planets is more populated than previously thought. As recently as 30 years ago, it appeared that the Solar System beyond Neptune was a barren place, but the discovery of the Kuiper Belt, a large population of comet-like bodies on the outer frontiers of the Solar System dethroned this notion. It could be that we are on the first steps towards a similar realization about the inner Solar System.
Palomar Observatory Received Funding to Protect Forest Health
By Rick Burruss (Palomar Observatory)
As a member of a collaborative effort to improve Palomar Mountain forest health, Palomar Observatory was recently awarded a grant from the state of California. The Forest Health Grant Program, initiated by the California Department of Forestry and Fire Protection (Cal Fire), targets restoring forest health, protecting watersheds, promoting long-term carbon storage, and minimizing the loss of forest carbon from large, destructive wildfires.
Working closely with the observatory, the partnership includes officials from Cal Fire, the United States Forest Service (USFS), USFS Cleveland National Forest (CNF), Forestry specialists from the United States Department of Agriculture, members of the Pauma Band of Mission Indians, La Jolla Band of Luiseño Indians, and other neighboring Palomar Mountain land owners. The grant was arranged, and will be managed by, the Fire Safe Council of San Diego County.
Caltech owns 2,029 acres near the pinnacle of Palomar Mountain. The contiguous observatory parcels were purchased by Caltech for the construction of Palomar Observatory in 1935. Of the 2,029 acres owned by Caltech, 1,690 is forested land. The remaining 339 acres contain observatory infrastructure, including paved and dirt roads spanning roughly 10 miles, buildings, domes, cottages for staff and families, water conveyance systems, electrical distribution systems, and large propane, diesel, and gasoline fuel systems. The forested areas within the observatory have not been actively managed, and fire has not impacted areas on or directly adjacent to the observatory in the past 200 years of recorded history.
Our proposal was submitted in November 2019. We learned that our proposal was accepted in January 2020, and was the highest rated out of all the 37 applicants (90 out of a possible 100 points). The grant compensates for work spanning 3 years, and will begin in the fall of 2020 (depending on potential delays due to the coronavirus).
Palomar Observatory will receive $950k of the total award of $5M. Forestry specialists provided technical and ecological assistance prior to submitting the proposal. They identified 312 acres of priority treatment areas on observatory grounds requiring mechanical thinning, mastication, and brush removal. Initial treatment includes a 31-acre fuel break enhancement along Palomar Truck Trail, which acts as the primary fire suppression access route along the upper ridge of Palomar Mountain. All brush and trees under 10 inches diameter (at breast height) will also be removed, with treatment extending 100 feet on either edge of the Trail. Trees within 10 feet of observatory structures will be trimmed back. A registered Professional Forester will be present to observe work as required. Cal Fire project planning review and final approval had been scheduled for September 2020 prior to project implementation; with preliminary mapping and habitat identification already underway. However that plan will be amended as necessary by COVID-19 response impacts.
COVID-19 Response
By Andy Boden (Caltech)
Like almost all facets of our lives, Palomar Observatory has been forced to respond to the COVID-19 pandemic by radically restructuring its operations. Since late February it had been clear that action would be required to protect staff and public safety during the emerging health crisis. Observatory management began meeting to discuss possible actions on 28 February, and on 18 March we executed our "phase 4" action to suspend Hale Telescope operations. That operations suspension remains our present status.
Happily, I can report that our smaller telescopes (the 48-inch Samuel Oschin Telescope and the 60-inch telescope) operate robotically, and we have been continuing science operations with them. As in our typical operational model, nighttime robotic operations with P48 and P60 are being monitored by our Hale Telescope operators (TOs), but now from the comfort of their couch rather than the Hale data room! I worry that once the TOs get used to monitoring the telescopes from home...
Thankfully our entire observatory staff report that they are all healthy and safe and sheltering in place. I similarly hope all of you read this note well and sheltered and provisioned.
Of course I share your regret in forgoing discovery opportunities during this operations suspension. But the present crisis will pass, and the observatory will return to operations and its typical high productivity as soon as it is safe and practical to do so. We are imagining what returning to operations might look like, and circumstances where we might be able to do so without risk to observatory personnel. We will continue to monitor the evolving situation and keep you informed of our plans to resume science operations with the Hale at Palomar Observatory.
Questions? We've answered many common visiting, media, and academic questions in our public FAQ page.
Please share your feedback on this page at the
COO Feedback portal.
Palomar Observer 6
Last updated: 22 April 2020 LY/AFB/ACM